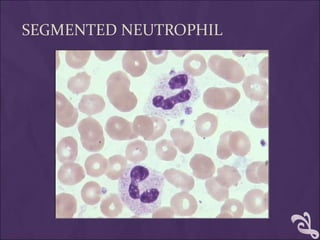
SEGMENTED NEUTROPHIL
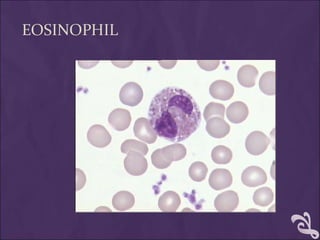
EOSINOPHIL
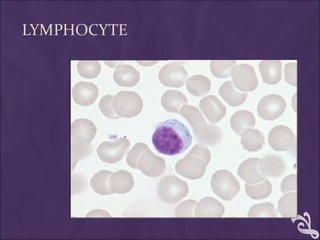
LYMPHOCYTE

This document provides information and instructions for making and examining a blood smear. There are three main types of blood smears: the cover glass smear, wedge smear, and spun smear. Additional types like the buffy coat smear are used for specific purposes. The document outlines the proper procedure for making a wedge smear from a blood sample and describes characteristics of a good smear. Common causes of a poor smear and biological factors that can affect the smear are also discussed. The document then covers slide fixation, staining using Leishman's stain, and examining the smear under the microscope to perform tasks like a manual differential count and assessing red blood cell morphology.